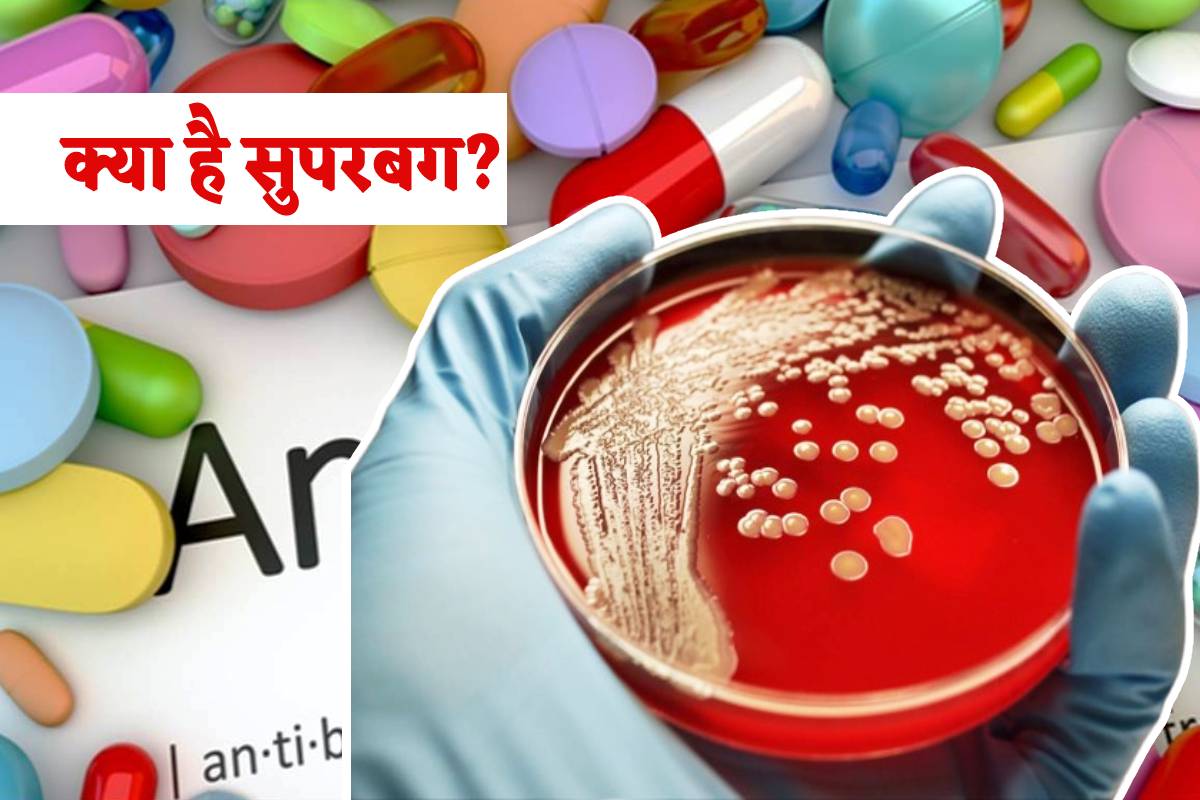

MP News Health ALert: एंटीबायोटिक्स के ज्यादा सेवन पर लगातार चेता रहे डॉक्टर...
MP News Health Alert: डॉक्टर से बिना परामर्श लिए एंटीबायोटिक दवाओं का अनावश्यक उपयोग या अनुचित तरीके से सेवन मुश्किलें पैदा कर सकता है। इससे शरीर में संक्रमण फैलाने वाले विभिन्न रोगजनक सुपरबग पैदा हो जाते हैं। विशेषज्ञ ने बताया कि ये लाइलाज हैं, क्योंकि इन पर कोई भी दवा असर नहीं करती जो जानलेवा हो सकता है। एम्स भोपाल सहित राजधानी और एमपी के अस्पतालोें में ऐसे मरीज पहुंच रहे हैं। उपचार के लिए उपयोग की गई विभिन्न दवाइयों के ठीक से डिस्पोज नहीं करने से भी सुपरबग पैदा होते हैं।
पिछले साल 2024 भारतीय चिकित्सा अनुसंधान परिषद (आइसीएमआर) की रिपोर्ट में देश के 21 नामचीन हॉस्पिटल के ओपीडी वार्ड से लेकर आइसीयू में भर्ती एक लाख मरीजों के रक्त, मलमूत्र, पस, मस्तिष्क व रीढ़ की हड्डी से संग्रह सीएसएफ नमूने की जांच में सुपरबग की श्रेणी के 10 तरह के घातक बैक्टीरिया पाए गए।
Updated on:
27 May 2025 12:27 pm
Published on:
27 May 2025 12:20 pm
बड़ी खबरें
View Allभोपाल
मध्य प्रदेश न्यूज़
ट्रेंडिंग
